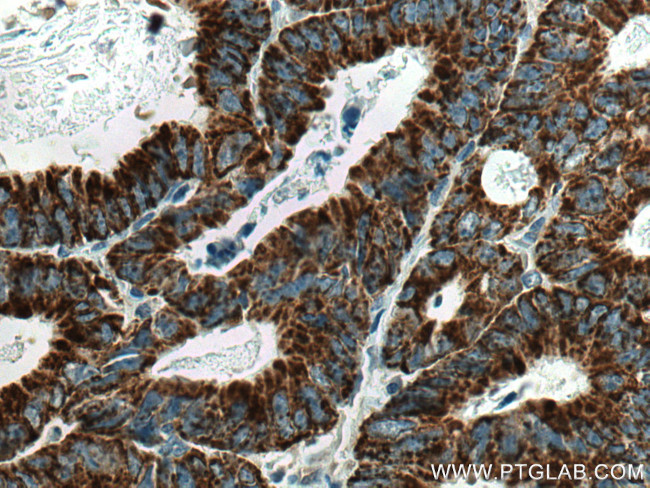
CNOT4 Antibody in Immunohistochemistry (Paraffin) (IHC (P))

Search
Proteintech
CNOT4 Monoclonal Antibody (4H5H3)
{{$productOrderCtrl.translations['antibody.pdp.commerceCard.promotion.promotions']}}
{{$productOrderCtrl.translations['antibody.pdp.commerceCard.promotion.viewpromo']}}
{{$productOrderCtrl.translations['antibody.pdp.commerceCard.promotion.promocode']}}: {{promo.promoCode}} {{promo.promoTitle}} {{promo.promoDescription}}. {{$productOrderCtrl.translations['antibody.pdp.commerceCard.promotion.learnmore']}}
产品信息
67798-1-IG
种属反应
宿主/亚型
分类
类型
克隆号
抗原
偶联物
形式
浓度
纯化类型
保存液
内含物
保存条件
运输条件
产品详细信息
Aliquoting is unnecessary for -20°C storage.
靶标信息
CNOT4 is a 575 amino acid protein with E3 ubiquitin ligase activity, mainly involved in protein modification and protein ubiquitination. It contains a ring type zinc finger domain of the C4C4 type, an RNA recognition motif and a bipartite nuclear localization signal.Studies show that CNOT4 is a component of the CCR4-NOT (CAF1) core complex that functions as general transcription regulation complex and has both a positive as well as a negative effect on the transcription of multiple functionally unrelated genes, thus controls gene expression. CNOT4 interacts with CNOT1 via C-terminus and with E2 ubiquitin ligases via C4C4 RING domain. Reports suggest that CNOT4 gets phosphorylated in response to DNA damage on consensus sites recognized by ATM and ATR.
仅用于科研。不用于诊断过程。未经明确授权不得转售。
篇参考文献 (0)
生物信息学
蛋白别名: CCR4-associated factor 4; CCR4-NOT transcription complex subunit 4; CCR4-NOT transcription complex, subunit 4; E3 ubiquitin-protein ligase CNOT4; negative regulator of transcription 4; NOT4 (negative regulator of transcription 4, yeast) homolog; Potential transcriptional repressor NOT4Hp; RING-type E3 ubiquitin transferase CNOT4; transcriptional repressor NOT4Hp
基因别名: CLONE243; CNOT4; NOT4; NOT4H; Not4hp
UniProt ID: (Human) O95628, (Mouse) Q8BT14
Entrez Gene ID: (Human) 4850, (Rat) 312227, (Mouse) 53621